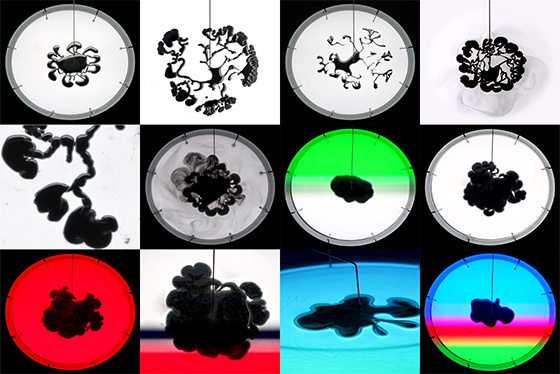

Выставка о новой материальности и экологии пройдет в Новой Третьяковке
Выставка о новой материальности и экологии пройдет в Новой Третьяковке
© Ralf Baecker
© Ralf Baecker 9 ноября в Западном крыле Новой Третьяковки Laboratoria Art&Science откроет выставку «New Elements», посвященную новой материальности и экологии.
Laboratoria Art&Science Foundation — первый в России некоммерческий исследовательский центр, целью которого является построение платформ междисциплинарного взаимодействия современного искусства, науки и технологий. В 2019 году Laboratoria стала резидентом Государственной Третьяковской галереи и открыла новое выставочное пространство в Западном крыле Новой Третьяковки.
Как сообщают организаторы выставки «New Elements», она предлагает взглянуть на мир как на аналоговый компьютер и представит 12 произведений художников из разных стран, которые покажут, как сократить разрыв между компьютерными данными и миром.
Три раздела экспозиции — «Аутографические измерения», «Вычисляя с природой» и «Цифровая материальность» — объединят художественные подходы, которые обращаются к материальным аспектам информации и вычислений в разных проявлениях: в природной среде, технологических системах или структурах нейронных сетей.
Участники выставки: Мемо Актен (Великобритания-Турция), Ральф Беккер (Германия), Эрих Бергер (Финляндия), Рёити Курокава (Япония), Tуула Наринен (Финляндия), Анна Ридлер (Великобритания), Томас Сарасено (Аргентина), Илья Федотов-Федоров (Россия), Tомас Фойерштайн (Австрия), Tереза Шуберт (Германия), Forensic Architecture (Великобритания).
Выставка «New Elements» в Западном крыле Новой Третьяковки продлится до 27 февраля 2022 года.